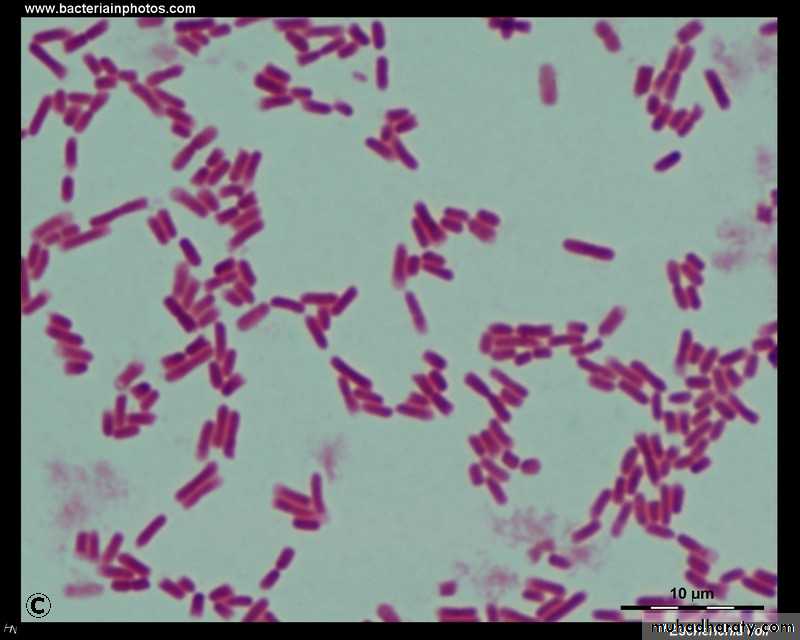

GRAM-NEGATIVE BACILLI THE ENTERICS:Family Enterobacteriaceae: Genus Escherichia & Genus Klebsiella
Department of Microbiology
College of Medicine
Baghdad University
Lec. 5, 2013-2014
Dr. Sarmad Zeiny
Objectives:
• Regarding genus E.coli & Klebsiella, Student should be able to:Describe the morphology & physiology.
Determine the virulence factors..
Analyze the diseases & pathogenicity.
Demonstrate the epidemiology/transmission.
Outline the laboratory diagnosis.
State the drug of choice and prophylaxis where regularly used.
THE ENTERICS
The ENTERICS are gram-negative bacteria that are part of the normal intestinal flora or cause gastrointestinal disease.
The main groups are Enterobacteriaceae, Vibrionaceae, Pseudomonadaceae and Bacteroidaceae.
These organisms are also divided into groups based upon biochemical and antigenic properties.
FAMILY ENTEROBACTERIACEAEEscherichia coli (E.coli)
• Structure and physiology:• E. coli is a gram negative bacilli or coccobacilli.
• Has fimbriae or pili.
• Most strains can ferment lactose.
• E. coli produces both acid and gas during fermentation of carbohydrates.
• They are all facultative anaerobes.
• Most strains are motile and not capsulated.
• They all ferment glucose.
• They are oxidase negative.
• Dry colonies on MacConkey’s agar.
Continuation of Structure and physiology:
Typing strains is based on differences in three structural antigens: O, H, and K .Gram Negative Bacilli
Reservoir:
• Human colon(normal flora); may colonize vagina or urethra.• Contaminated crops where human fecal fertilizer is used.
• Enterohemorrhagic strains: bovine feces.
Transmission:
• Endogenous.• Fecal-oral.
• Maternal fecal flora.
• Enterohemorrhagic strains: bovine fecal contamination (raw or under cooked beef, milk, apple juice from fallen apples).
Nonpathogenic Escherichia coli (normal
flora) + Virulence factors = DISEASE.Virulence factors :
1) Mucosal interaction:a) Mucosal adherence with pili (colonization factor).
b) Ability to invade intestinal epithelial cells.
2) Exotoxin production:
a) Heat-labile and stable toxin (LT and ST).
b) Shiga-like toxin (verotoxin) inhibit 60S(protein)
3) Endotoxin: Lipid A portion of lipopolysaccharide ( LPS).
4) Iron-binding siderophore: obtains iron from human transferrin or lactoferrin.
Diseases:
1) Diarrhea(most common cause in infantile )..
2) Urinary tract infection (most common cause).
3) Neonatal meningitis (2nd most common cause).
4) Gram-negative sepsis, occurring commonly in debilitated hospitalized patients(most common cause).
E. coli Diarrhea:
• Strain of E.coli• Abbreviation
• Syndrome
• Transmission
• Enterotoxigenic E. coli
• ETEC
• Watery diarrhea (traveler’s diarrhea)
• Fecal /oral
• Enteropathogenic E. coli
• EPEC
• Watery diarrhea of long duration,
• mostly in infants, often in developing countries
• Fecal /oral
• (2nd most common infantile diarrhea)
• Enterohemorrhagic E. coli
• (O157:H7) MOST COMMON, O104:H4 CUCMBER E.COLI
•
• EHEC (VTEC)
• Bloody diarrhea; Hemorrhagic colitis and
• hemolytic uremic syndrome (HUS)
• Bovine Feces, Pitting Zoos
• Enteroinvasive E. coli
• EIEC
• Bloody diarrhea
• Fecal /oral
• Enteoaggregatirve E. coli
• O104:H4
• EAEC
• Persistent watery diarrhea in children
• and patients infected with HIV
• Fecal /oral
• Diffusely adherent E.coli
• DAEC
• Watery diarrhea
• Fecal /oral
Methods of differentiating pathogenic E.coli from normal flora :
Immunoassay looking for specific protein antigen (on or excreted from the bacterium).Serotyping since certain serotypes are more often Pathogenic.
DNA probe for specific gene in a culture.
PCR for clinical specimen.
Genus Klebsiella
• Genus Features:Gram-negative rods.
Enterobacteriaceae.
Major capsule.
•
• Species of Medical Importance:
• Klebsiella pneumoniae
Klebsiella pneumoniae
Distinguishing Features:Gram-negative rods with large polysaccharide capsule. Non motile.
Mucoid, lactose-fermenting colonies on MacConkey's agar.
Oxidase negative.
Reservoir: human colon (normal flora) and upper respiratory tract.
Transmission: endogenous.
Pathogenesis (virulence factors):
Capsule impedes phagocytosis.
Endotoxin: causes fever, inflammation, and shock (septicemia).
Diseases:
Pneumonia• - Community-acquired,
Chronic lung disease, alcoholism, or diabetes,
Endogenous;
Frequent abscesses make it hard to treat; fatality rate high
bloody (currant jelly).
• b) Urinary tract infections :-catheter-related (nosocomial) from fecal contamination of catheters.
• C) Septicemia:-in immunocompromised patients may originate from bowel defects or invasion of IV lines.
Summary/ conclusions:
E.coli & Klebsiella are G-ve rods.E. coli has fimbriae or pili.
Klebsiella has capsule.
Nonpathogenic E.coli (normal flora) + Virulence factors = DISEASE.
Klebsiella causes diseases in abnormal conditions like catheters, chronic lung disease...etc
Antibiotic sensitivity testing of isolates is necessary to determine the appropriate choice of drugs.